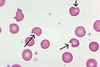

MKSAP Flashcards
(29 cards)
This should be considered in skin and subcutaneous infectious with chronic purulent drainage, lack of convincing pathogen on routine culture, and association with implanted prosthetic devices
rapidly growing mycobacteria
pseudo gout findings on xray
chondrocalcinosis
Secondary causes of pseudogout
Hyperparathyroidism Hypothyroidism Hypophosphatasia Hypomagnesemia Hemochromatosis **pseudogout is more common in older adults, so if it presents in a younger person should look into secondary causes
Women who receive chest wall radiation before the age of – years, breast cancer screening should begin at age – years or – years after completion of radiation therapy.
30 25 8
How do you distinguish between true aortic stenosis versus pseduostenosis?
Dobutamine echocardiography
What is the most common cause of malaria? What does it look like on light microscopy?
Plasmodium falciparum “banana-shaped” gametocytes along the periphery of erythrocytes
Kidney transplant recipients who are trying to get pregnant should stop mycophenolate mofetil, sirolimus and switch to –.
Azathioprine- generally safer and well tolerated during pregnancy
How to treat empyemas?
Instillation of intrapleural tissue plasminogen activator- deoxyribonuclease
How does saline-responsive metabolic alkalosis typically present? What are the most common causes?
Hypovolemia Low urine chloride (<15mEq/L) Most common causes: vomiting, nasogastric suction, diuretic use
Type 1 amiodarone-induced thyrotoxicosis - Occurs in which patients? - Findings on doppler US?
Type 1 (hyperthyroidism) amiodarone-induced thyrotoxicosis occurs in patients with underlying multinodular goiter or latent Graves disease. Increased vascularity on color flow Doppler US
Type 2 Amiodarone induced thyrotoxicosis - Occurs in which patients? - Findings on doppler?
Type 2 (destructive thyroiditis) Effects patients w/o thyroid disease NOT associated w/ increase vascularity on doppler
Name of slow-growing melanoma most commonly seen on sun-exposed skin of older fair-skinned persons.
Lentigo maligna
How to treat valvular atrial fibrillation in terms of anticoagulation? What is the definition of valvular Afib?
Warfarin, regardless of CHA2DS2-VASc score. Valvular atrial fibrillation refers to atrial fibrillation in the setting of moderate to severe mitral stenosis or in the presence of a mechanical heart valve.
How to diagnose SIBO
Jejunal aspirate culture or glucose hydrogen breath testing
Most thyrotoxic patients benefit from —- to reduce adrenergic symptoms.
Beta blockers- metoprolol or atenolol are preferred
Urticarial vasculitis differs from urticaria in that 1– 2–
- individual lesions persist longer than 24 hours. 2. Urticarial vasculitis more commonly presents with painful or burning lesions instead of pruritus and leave bruise-like changes when they resolve.
Amyopathic dermatomyositis presents with…. it carries risks for…
Amyopathic dermatomyositis presents with skin findings characteristic of dermatomyositis, but without clinical or laboratory evidence of muscle disease; it carries risks for underlying malignancy.
What is Actinic purpura?
Actinic purpura is caused by age-related capillary fragility and bleeding under atrophic skin; minor trauma can cause impressive purpuric macules and patches, most commonly on the forearm.
Gold standard for diagnosis of microscopic polyangiitis? (Two options)
- biopsy demonstrating nongranulomatous necrotizing pauci-immune vasculitis of small vessels OR 2. -immune necrotizing crescentic glomerulonephritis in the kidney.
What antibody is positive in microscopic polyangiitis?
positive p-ANCA (directed against myeloperoxidase)
What antibody is positive in Granulomatosis with polyangiitis ?
positive c-ANCA (directed against proteinase-3
Paroxysmal Nocturnal Hemoglobinuria Presenting symptoms: Clinical findings: Pathophys: Diagnosed by:
Presenting symptoms: fatigue, abdominal pain Clinical findings: pancytopenia, intravascular hemolysis, hemoglobinuria Pathophysiology: mutation in gene that regulates production of glycophosphatidylinositol anchoring proteins. These proteins on leukocytes normally prevent complement activation Diagnosed by: flow cytometry will demonstrate abscense of proteins
What condition is characterized by inflammatory abscesses, sinus tracts, and scarring in intertriginous areas? What three things is this condition associated with?
Hidradenitis suppurativa Obesity, smoking, metabolic syndrome
Anti-eleptics to use during pregnancy (two)
Levetiracetam Lamotrigine